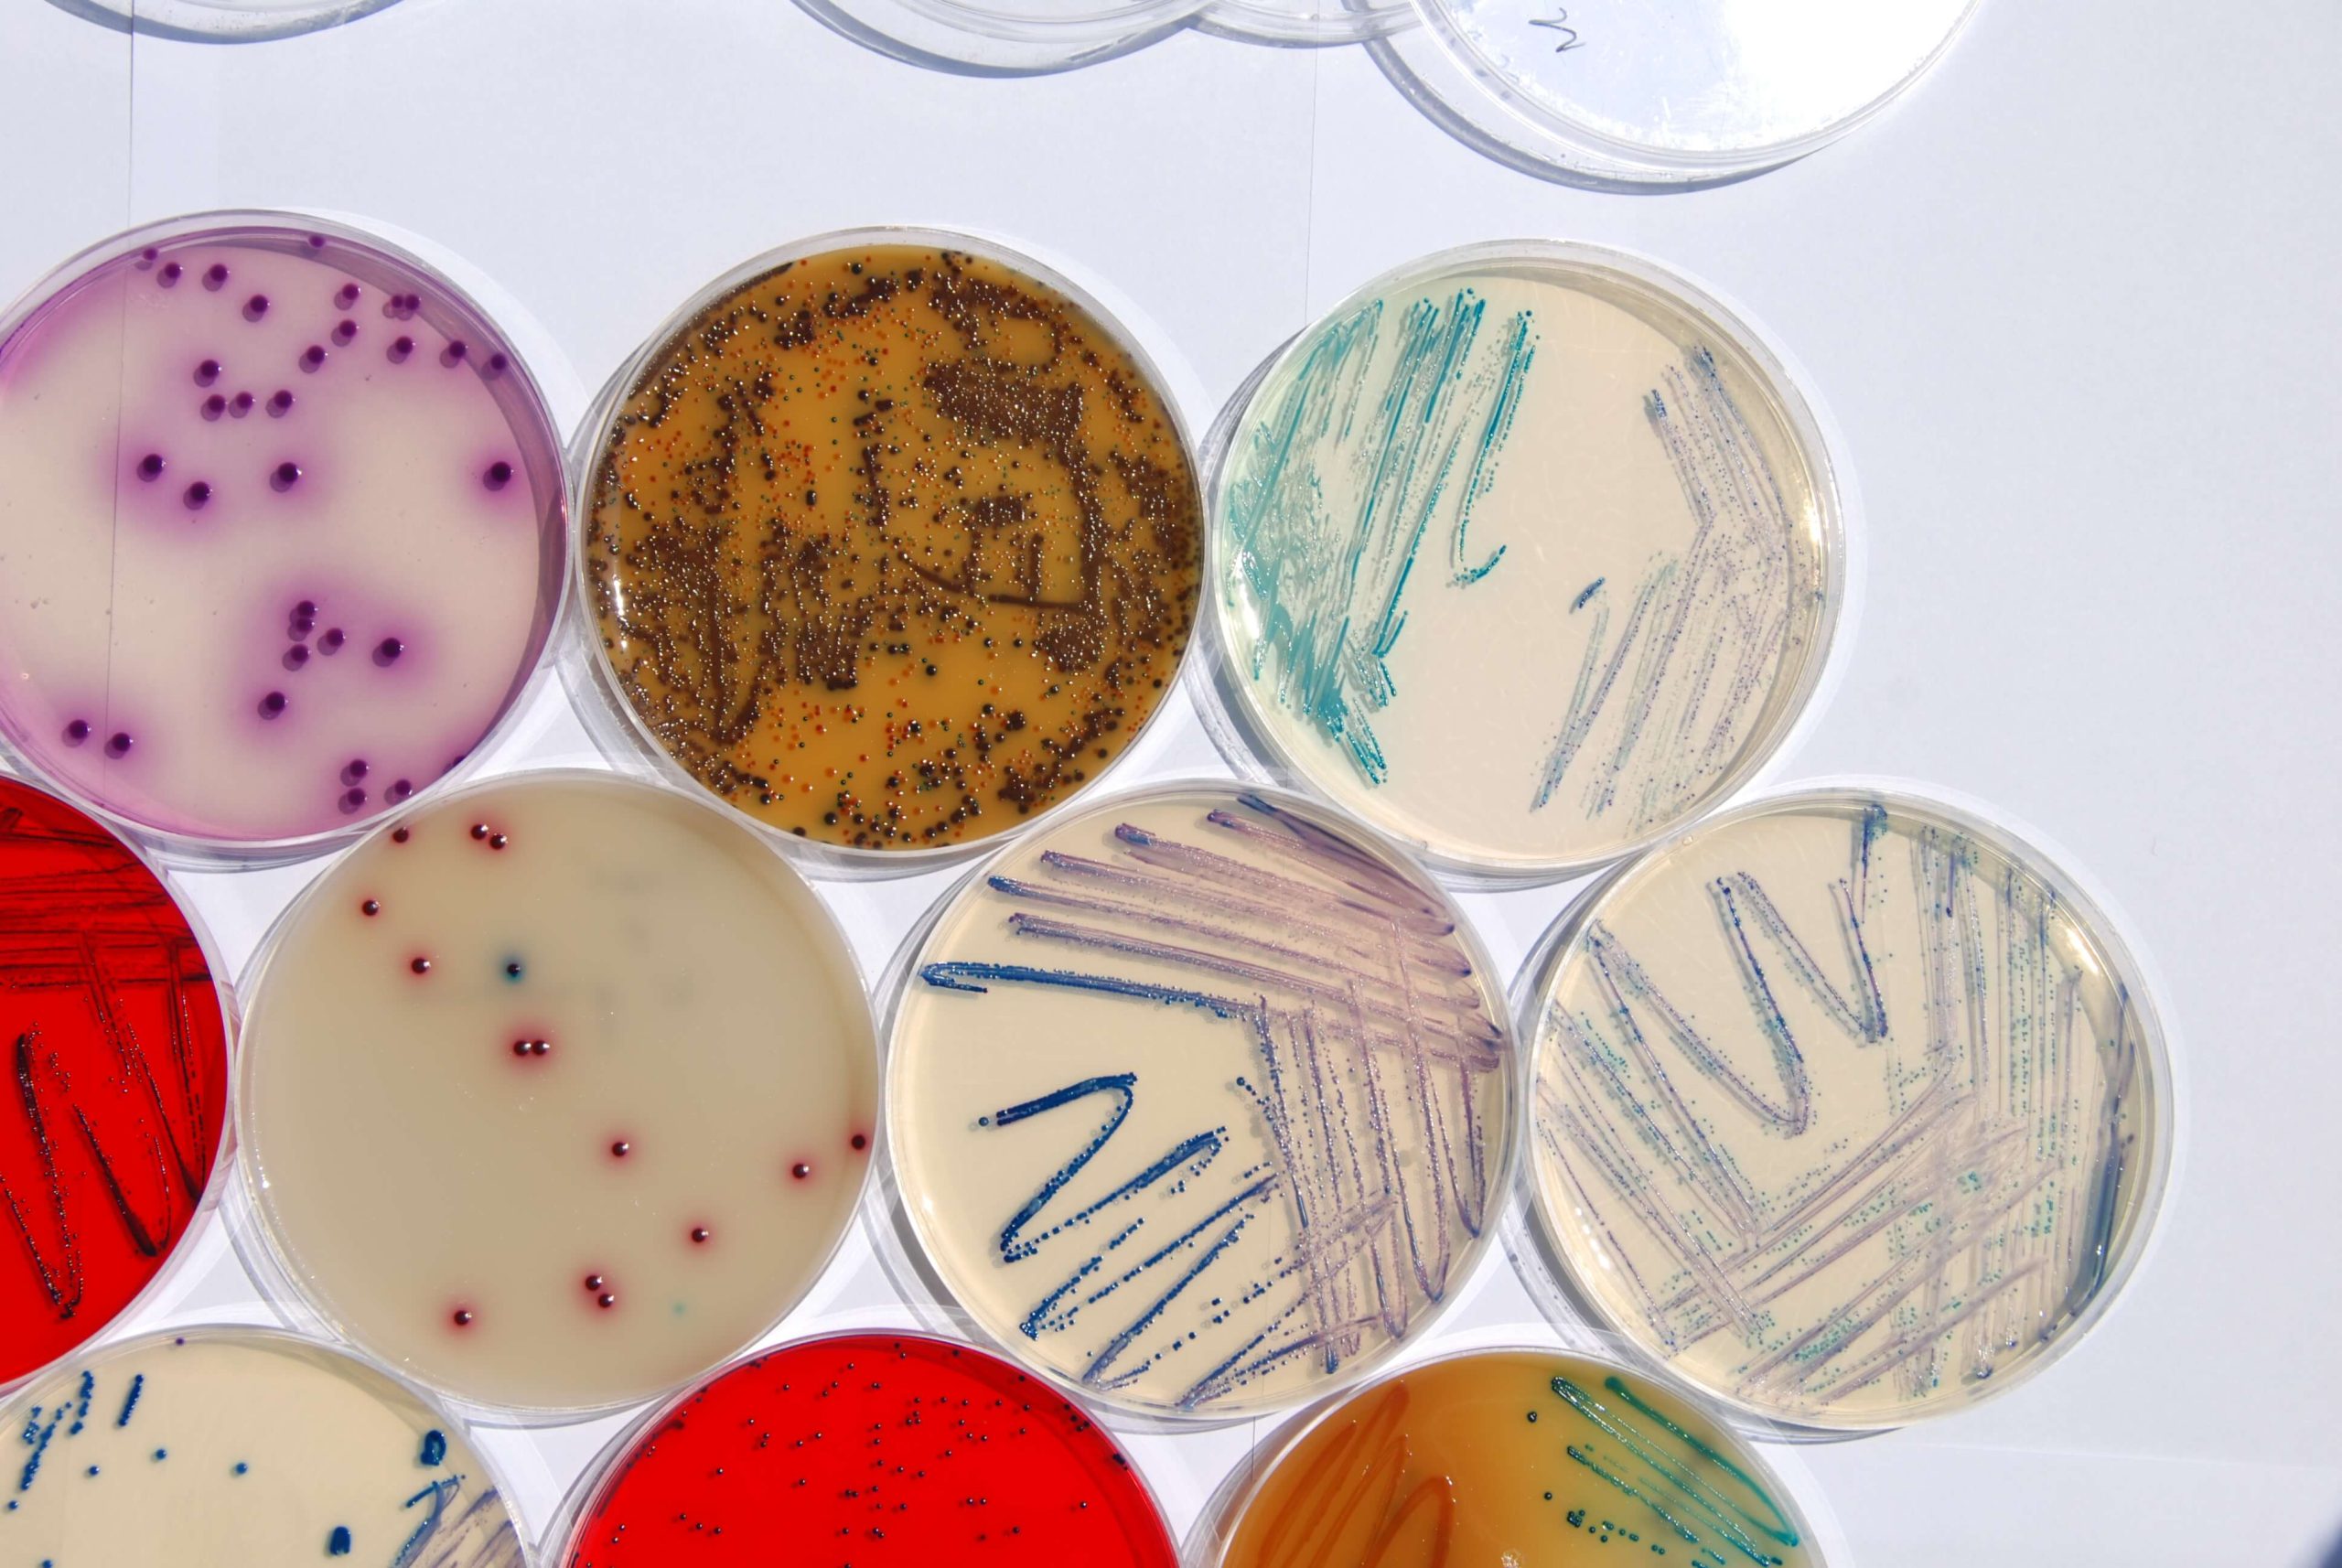

Microbiology
Culture Media
Prepared media are manufactured in our production facility, equipped with modern production lines. This provides our company with a high production efficiency and ensures product quality which conforms with the requirements established in the European legislation. Our Quality System is certified to ISO 9001 and ISO 13485 for the design and manufacture of medical devices. The culture media meet the standards of Directive 98/79/CE (1998/10/27) related to medical devices for invitro diagnostic use. Each lot of prepared media is tested with control strains for growth and (when required) for inhibition. Lot that meets all standards receive The Quality Control Certificate.
Category: Microbiology
Tag: Biomaxima